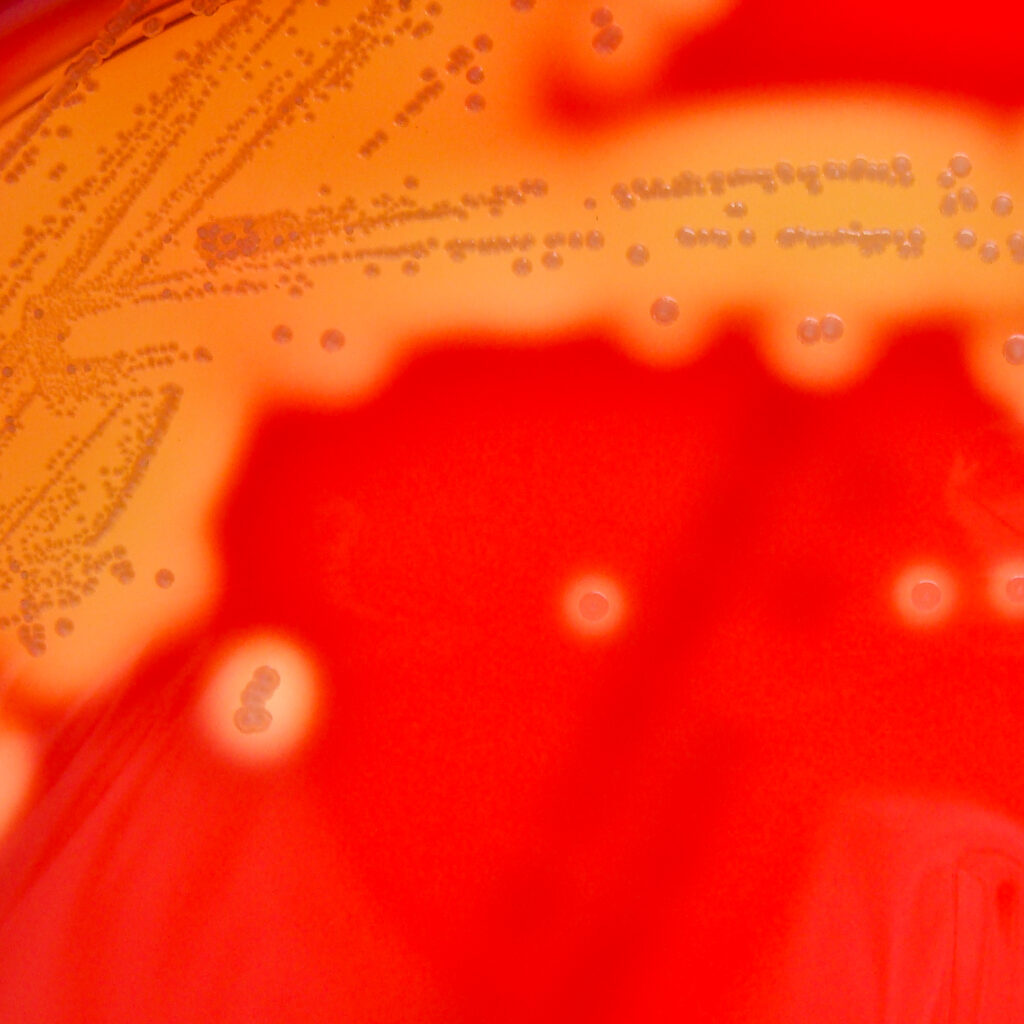

The information provided was valid at the time of the publication of this CPD article.
Group A streptococcus is a common bacteria that has garnered a lot of media attention in recent months, and has created high levels of anxiety, particularly among parents of young children.
In this month’s CPD article Marie Philbin, Chief Antimicrobial Pharmacist of the National Antimicrobial Resistance and Infection Control Team at the HSE, provides an overview of Group A streptococcus, including the types of infections it causes, how it spreads, and current epidemiology in Ireland.
Group A streptococcus is a common bacteria. Lots of us carry it in our throats and on our skin and it doesn’t always result in illness. However, Group A streptococcus does cause a number of infections, some mild and some more serious.
The most serious infection caused by Group A streptococcus occurs when it becomes invasive (invasive group A strep). That is when the bacteria gets into parts of the body where it is not normally found, such as the lungs or bloodstream. This is called invasive Group A Strep (iGAS) and in rare cases it can be fatal.
Group A streptococcus causes infections in the skin, soft tissue and respiratory tract. It’s responsible for infections such as tonsillitis, pharyngitis, scarlet fever, impetigo and cellulitis among others.
While infections like these can be unpleasant, they rarely become serious. When treated with antibiotics, an unwell person with a mild illness like tonsillitis stops being contagious around 24 hours after starting their medication.
A common presentation of Group A streptococcus in children can be scarlet fever which causes the following symptoms: fever, a raised rash which can feel rough to the touch like sandpaper, sore throat, and a swollen tongue.
The first signs of scarlet fever can be flu-like symptoms, including a high temperature, a sore throat and swollen neck glands.
A rash appears 12 to 48 hours later. It looks like small, raised bumps and starts on the chest and tummy, then spreads. The rash makes your skin feel rough, like sandpaper. The rash will be less visible on darker skin but will still feel like sandpaper. More information on scarlet fever can be found at www.hse.ie > Health A to Z > S, and www.hspc.ie > Topics A – Z > S.
The most serious infections linked to Group A streptococcus come from invasive group A strep, known as iGAS.
This can happen when a person has sores or open wounds that allow the bacteria to get into the tissue, or inside the body, where a person has damage to their respiratory tract after a viral illness, or in a person who has a health condition that reduces their immunity to infection.
When the immune system is compromised, a person is more vulnerable to severe, invasive disease.
Necrotising fasciitis, necrotising pneumonia and Streptococcal Toxic Shock Syndrome are some of the most severe, but rare, forms of iGAS.
Group A streptococcus is spread by close contact with an infected person and can be passed on through coughs and sneezes, or from a wound.
Some people can have the bacteria present in their body without feeling unwell or showing any symptoms of infections, and while they can pass it on, the risk of spread is much greater when a person is unwell.
Where a patient presents with tonsillitis/pharyngitis/sore throat, Strep A may be a factor.
However, the majority of tonsillitis/pharyngitis/sore throat infections are caused by viruses and symptom management (e.g., with simple analgesics), can be recommended. Pharmacists are well placed to offer self-care advice and treatments. Patients can also be directed to the sore throat section on the HSE website, www.undertheweather.ie .
Group A streptococcus causes 10-20% of adult pharyngitis; and 20-30% of infections in children. Treatment is generally only required when there is clinical evidence of infection.
Therefore, it is important to recognise the FEVERPAIN scoring system when managing pharyngitis as it helps to identify those patients where Strep A infection may be present and who would be most likely to benefit from antibiotics.
Part of this scoring tool recommends the use of a delayed prescription. It is advisable to check with patients presenting with delayed prescriptions that the patient is adhering to the prescriber recommendation of only requesting dispensing of the prescription for immediate consumption, and not just to keep at home ‘just in case’.
Group A streptococcus (also known as Streptococcus pyogenes) remains sensitive to penicillins and cephalosporins. It is for this reason that the most narrow spectrum penicillin, phenoxymethylpenicillin, is the recommended first-line agent.
Cefalexin, the most narrow spectrum cephalosporin, is a suitable alternative if phenoxymethylpenicillin cannot be tolerated for reasons other than an allergy to penicillin. In patients with a genuine penicillin allergy, then clarithromycin is a recommended agent, however resistance to this, and other macrolides (erythromycin & azithromycin), is increasing in Group A streptococcus.
Due to the supply challenges over recent weeks (December 2022/January 2023), amoxicillin has been added as an additional option to the list of recommended agents for pharyngitis/tonsillitis on www.antibioticprescribing.ie. Amoxicillin is a much broader spectrum agent than phenoxymethylpenicillin or cefalexin, and so once the availability of antibiotics has stabilised, this option will be removed.
In general, the recommended duration of treatment of antibiotics for pharyngitis/tonsillitis is five days, unless the patient has features of scarlet fever, where a recommended duration of 10 days is advised.
There has been an increase in notified iGAS infections in Ireland since October 2022. Of the 114 iGAS cases notified between 1 January 2022 and 10 January 2023, 77 (or 68%) have been reported since 1 of October 2022. Of these 77 cases, 25 (or 32%) were in children aged under 10 years old, with a further four cases in children aged 10-17 years.
In a normal year, iGAS infections typically peak during the first six months. The increase observed towards the end of 2022 is the first time a peak has been reported outside this usual peak period. During the pandemic, normal social mixing patterns were interrupted which led to changes in how diseases such as iGAS presented.
Since October 2022, there have been four deaths in children: three deaths in children aged under 10 years old, and one death in a child aged 10-17 years. There have been no deaths to date in 2023.
A HSE incident management team has been formed and the epidemiological situation is being monitored closely.
A number of countries are seeing increases in iGAS, especially in children. The UK is seeing a significant upsurge. While cases are increased in Ireland, they have not increased to the same extent as in the UK.
The Irish Meningococcal and Sepsis Reference Laboratory (based in Children’s University Hospital, Temple Street) are currently carrying out investigations to determine if a particular strain of Group A streptococcus (or Strep A) is responsible for the increase in iGAS infections in children, and in the wider population in Ireland.
There have been reports of similar increases in iGAS infections amongst paediatric patients in other countries, including the Netherlands and France. The reason for such increases is not fully understood as yet. There is likely a combination of factors, including increased social mixing compared to the previous years as well the effects of higher levels of respiratory viruses such as COVID-19, flu and RSV.
It is always concerning when a child is unwell. Group A streptococcus infections cause various symptoms such as sore throat, fever, chills and muscle aches. If a parent feels their child is seriously unwell, they should be advised to trust their own judgement.
Contact your GP if:
Call 999 or go to an Emergency Department if:
Good hand and respiratory hygiene are important for stopping the spread of many bugs. By teaching children how to wash their hands properly with soap and warm water for 20 seconds, using a tissue to catch coughs and sneezes, and keeping away from others (and out of childcare or school) when they are feeling unwell, they will be able to reduce the risk of picking up, or spreading, infections.
Keeping child up to date with their vaccines will also help them to keep well. Data from the UK over a four-year period suggests that the nasal flu vaccine may reduce Strep A infections in children.
Useful links
Marie Philbin

Share This Page